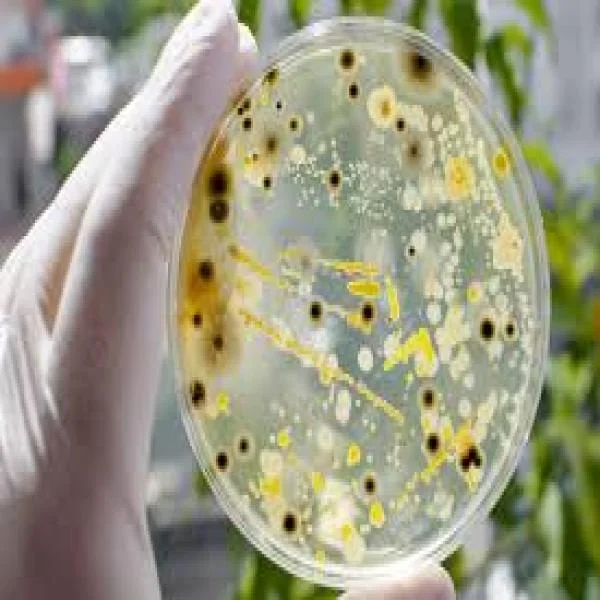
Ép Khuẩn: Giải Pháp Tăng Cường Sức Khỏe Tôm Trong Nuôi Trồng Thủy Sản

Thách thức và cơ hội trong ngành nuôi tôm Việt Nam
Sự Quan Trọng của Ngành Nuôi Tôm trong Nền Kinh Tế Việt Nam
Ngành nuôi tôm Việt Nam không ngừng phát triển và đóng góp một phần quan trọng vào nền kinh tế của đất nước. Trong bài viết này, chúng ta sẽ xem xét những tiến bộ quan trọng nhờ công nghệ cao trong ngành nuôi tôm và cách nó đã giúp đảm bảo sự phát triển bền vững của ngành này.
Sự Thăng Tiến của Ngành Nuôi Tôm và Những Thách Thức
Trong vài năm gần đây, ngành nuôi tôm tại Việt Nam đã trải qua sự tăng trưởng ngoạn mục. Xuất khẩu tôm đã tăng đáng kể, và ngành này đang đứng ở vị trí quan trọng trong nền kinh tế xuất khuẩn thủy sản của Việt Nam. Một trong những tháng gần đây, xuất khẩu tôm của Việt Nam đạt hơn 442 triệu USD, tăng 47% so với cùng kỳ năm trước. Tổng kim ngạch xuất khẩu tôm trong bốn tháng đầu năm đã đạt mức kỷ lục trong 5 năm với 1,4 tỷ USD, tăng 45% so với cùng kỳ. Điều này thể hiện rõ sức mạnh và tiềm năng của ngành nuôi tôm Việt Nam.
Mặc dù có thành tích đáng tự hào, năm 2023 mang lại những thách thức mới. Việc cạnh tranh với các đối thủ như Ecuador và Ấn Độ trở nên khó khăn hơn. Ecuador dự kiến sản lượng tôm của họ sẽ vượt quá 1,5 triệu tấn, gấp đôi sản lượng tôm thẻ chân trắng của Việt Nam (hơn 700.000 tấn). Với những khó khăn tiềm ẩn như vậy, sẽ cần sự đổi mới và nâng cấp liên tục trong ngành nuôi tôm.
Công Nghệ Cao - Bước Đột Phá Trong Ngành Nuôi Tôm
Để đối phó với các thách thức này, ngành nuôi tôm Việt Nam đã áp dụng công nghệ cao một cách đáng kể để nâng cao hiệu quả sản xuất. Công nghệ cao đã chứng minh vai trò quan trọng của nó trong việc giám sát và kiểm soát chất lượng nước trong các bể nuôi tôm, quản lý bệnh tật, cũng như cải thiện chất lượng thức ăn và sức khỏe của tôm.
Các Mô Hình Ứng Dụng Công Nghệ Cao trong Nuôi Tôm
Công nghệ cao đã mở ra nhiều mô hình ứng dụng đột phá trong ngành nuôi tôm:
- Mô hình Nuôi RAS (Tuần Hoàn Nước): Đây là mô hình nuôi tôm trong môi trường tuần hoàn khép kín. Nước chỉ được cung cấp một lần và sau đó được lọc và tái sử dụng liên tục. Mô hình này giúp hạn chế dịch bệnh và tiết kiệm nguồn nước.
- Mô hình Nuôi Biofloc: Mô hình này tạo ra các hạt floc lơ lửng trong ao nuôi, chúng xử lý chất thải hữu cơ và trở thành nguồn thức ăn tự nhiên cho tôm. Công nghệ này không chỉ giúp tiết kiệm lượng thức ăn mà còn ổn định môi trường nước.
- Mô hình Nuôi CPF-Combine 3 Giai Đoạn: Mô hình này kết hợp nhiều giải pháp như an toàn sinh học, môi trường nuôi sạch, sử dụng con giống sạch bệnh và thức ăn chất lượng.
Thách Thức và Triển Vọng
Mặc dù đã đạt được nhiều thành tựu, việc ứng dụng công nghệ cao trong nuôi tôm vẫn đối mặt với nhiều thách thức. Các hộ nuôi tôm cần đối mặt với việc đầu tư lớn và cần chuyển giao công nghệ một cách hiệu quả. Mô hình nuôi tôm siêu thâm canh cũng đặt ra nhiều thách thức đối với việc quản lý mật độ và kiểm soát dịch bệnh.
Tuy nhiên, với lòng sáng tạo và tận dụng công nghệ cao, ngành nuôi tôm Việt Nam đã và đang thể hiện sự sẵn sàng đối mặt với những thách thức. Công nghệ cao không chỉ là một công cụ hữu ích mà còn là bước đột phá quan trọng trong việc đảm bảo sự phát triển bền vững của ngành nuôi tôm.